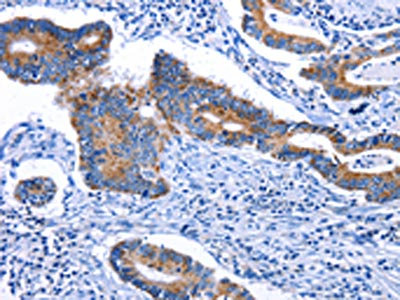

STAT5A Antibody
-
中文名稱:STAT5A兔多克隆抗體
-
貨號(hào):CSB-PA554957
-
規(guī)格:¥1100
-
圖片:
-
The image on the left is immunohistochemistry of paraffin-embedded Human thyroid cancer tissue using CSB-PA554957(STAT5A Antibody) at dilution 1/25, on the right is treated with fusion protein. (Original magnification: ×200)
-
The image on the left is immunohistochemistry of paraffin-embedded Human colon cancer tissue using CSB-PA554957(STAT5A Antibody) at dilution 1/25, on the right is treated with fusion protein. (Original magnification: ×200)
-
Gel: 10%SDS-PAGE, Lysate: 30 μg, Lane: Human fetal lung tissue, Primary antibody: CSB-PA554957(STAT5A Antibody) at dilution 1/450, Secondary antibody: Goat anti rabbit IgG at 1/8000 dilution, Exposure time: 30 seconds
-
-
其他:
產(chǎn)品詳情
-
Uniprot No.:
-
基因名:
-
別名:MGF antibody; Signal transducer and activator of transcription 5A antibody; Signal Transducer and Activator of Transcription 5B antibody; STA5A_HUMAN antibody; STAT 5A antibody; STAT 5B antibody; STAT5 antibody; STAT5A antibody; STAT5B antibody; Transcription factor STAT5A antibody; Transcription factor STAT5B antibody
-
宿主:Rabbit
-
反應(yīng)種屬:Human,Mouse,Rat
-
免疫原:Fusion protein of Human STAT5A
-
免疫原種屬:Homo sapiens (Human)
-
標(biāo)記方式:Non-conjugated
-
抗體亞型:IgG
-
純化方式:Antigen affinity purification
-
濃度:It differs from different batches. Please contact us to confirm it.
-
保存緩沖液:-20°C, pH7.4 PBS, 0.05% NaN3, 40% Glycerol
-
產(chǎn)品提供形式:Liquid
-
應(yīng)用范圍:ELISA,WB,IHC
-
推薦稀釋比:
Application Recommended Dilution ELISA 1:500-1:5000 WB 1:500-1:2000 IHC 1:25-1:100 -
Protocols:
-
儲(chǔ)存條件:Upon receipt, store at -20°C or -80°C. Avoid repeated freeze.
-
貨期:Basically, we can dispatch the products out in 1-3 working days after receiving your orders. Delivery time maybe differs from different purchasing way or location, please kindly consult your local distributors for specific delivery time.
-
用途:For Research Use Only. Not for use in diagnostic or therapeutic procedures.
相關(guān)產(chǎn)品
靶點(diǎn)詳情
-
功能:Carries out a dual signal transduction and activation of transcription. Mediates cellular responses to the cytokine KITLG/SCF and other growth factors. Mediates cellular responses to ERBB4. May mediate cellular responses to activated FGFR1, FGFR2, FGFR3 and FGFR4. Binds to the GAS element and activates PRL-induced transcription. Regulates the expression of milk proteins during lactation.
-
基因功能參考文獻(xiàn):
- HSP27 is a partner of JAK2-STAT5 and a potential therapeutic target in myelofibrosis. PMID: 29650953
- the two cell lines exhibited relatively low protein expression levels of p53, lower levels of p53 and TPp53BP1 transcripts were detected in the K562/G cells. Taken together, these findings suggest that the resistance of CML to the tyrosine kinase inhibitor, imatinib, may be associated with persistent STAT5-mediated ROS production, and the abnormality of the p53 pathway PMID: 29115375
- Peripheral blood Tregs failed to effectively utilize IL-2 and had relatively little STAT5 phosphorylation in active ankylosing spondylitis. PMID: 27901054
- These results indicate that IL-3 regulates endothelial cells-extracellular vesicles release, cargo and IL-3 angiogenic paracrine action via STAT5. PMID: 27157262
- Similar to normal developmental programs, oncogenic functions of STAT5 rely on molecular crosstalk with PI3K/AKT signaling for the initiation, and in some instances the progression, of breast cancer. (Review) PMID: 28495456
- we demonstrated that Imatinib mesylate (IM)impaired T cell survival through the inhibition of IL-7 and STAT5-p but not TCR signaling which remained unaffected during IM therapy. Thus, off-target inhibitory effects of IM on IL-7 and STAT5-p explain how T cell lymphopenia occurs in patients treated with IM. PMID: 28387753
- Our results suggest the regulation of STAT5A via epigenetic mechanisms during normal pregnancy and the association of STAT5A epigenetic dysregulation in pregnancy related complications PMID: 27452437
- Two p53 binding sites were mapped in the STAT5A gene and named PBS1 and PBS2; these sites were sufficient to confer p53 responsiveness in a luciferase reporter gene. PMID: 26876578
- STAT3/miR-211/STAT5A signaling plays a key role in mesenchymal stem cell migration. PMID: 27145179
- Stat5 activation increased the DNA binding activity of NF-kappaB though binding of p-Stat5 and p-RelA in nucleus. PMID: 27027438
- This is the first report of a survival disadvantage of EBV+ patients with CLL, and the first time that STAT5b expression is correlated with survival. The correlation of STAT5 expression with the presence of the virus, along with our survival correlations defines a subgroup of patients with CLL that may benefit from anti-STAT agents. PMID: 27367207
- STAT5 signaling axis drives abnormal cell proliferation in autosomal dominant polycystic kidney disease. PMID: 28104302
- O-GlcNAcylation and tyrosine phosphorylation act together to trigger pYSTAT5 levels and oncogenic transcription in neoplastic cells. A mutated hyperactive gain-of-function (GOF) STAT5 without O-GlcNAcylation resulted in decreased tyrosine phosphorylation, oligomerization and transactivation potential and complete loss of oncogenic transformation capacity. PMID: 28074064
- STAT5 interacted with minichromosome maintenance (MCM) complex, suggesting that STAT5 directly facilitates viral DNA replication by recruiting the helicase complex of the cellular DNA replication machinery to viral DNA replication centers. PMID: 28459842
- High STAT5 phosphorylation is associated with systemic lupus erythematosus. PMID: 28254841
- NPM1 downregulation by P-STAT5 is mediated by impairing the BRCA1-BARD1 ubiquitin ligase, which controls the stability of NPM1. In turn, decreased NPM1 levels led to suppression of p53 expression, resulting in enhanced cell survival. PMID: 28005077
- High STAT5A expression is associated with B-lymphoblastic lymphoma with inflammation. PMID: 27018255
- Results provide evidence that HDAC6 could regulate HMGN2 acetylation levels and binding to Stat5a-responsive promoters, and therefore, Stat5a transcriptional activity in breast cancer cells. PMID: 27358110
- Sustained STAT5 transcription factor (STAT5) phosphorylation is necessary to induce long-term interleukin 2 receptor subunit alpha (CD25) expression in T lymphocytes. PMID: 27936140
- BCR/ABL positively regulates the expression of EZH2 via STAT5 signaling. PMID: 27070757
- these results demonstrate that the oncogenic signal transducer and activator of transcription 5/Akt pathway is a cellular target for indole-3-carbinol in chronic myeloid leukemia cells. Thus, this clinically tested natural compound can be a potential candidate in the treatment of chronic myeloid leukemia following confirmation with clinical studies PMID: 28631564
- elucidate a novel mechanism whereby the linker histone H1 prevents STAT5 binding at promoter DNA, and the PRL-induced dissociation of H1 mediated by HMGN2 is necessary to allow full STAT5 recruitment and promote the biological effects of PRL signaling PMID: 28035005
- These results reveal a novel role of IL-7 and IL-15 in maintaining human T cell function, provide an explanation for T cell dysfunction in humanized mice, and have significant implications for in vitro studies with human T cells. PMID: 27855183
- STAT5 activation in the dermal papilla is important for hair follicle growth inductaion. PMID: 27131881
- Data show that signal transducer and activator of transcription 5 STAT5A and STAT5B have distinctive and potentially important roles in regulation of hepatic drug response genes as well as in contributing to gender-related differences in expression of hepatic cytochrome P450s (CYPs) and transcription factors (TFs). PMID: 27264955
- findings establish a central role for STAT5 activation in the pathogenesis of juvenile myelomonocytic leukemia PMID: 27418650
- Although inappropriate promoter methylation was not invariantly associated with reduced transcript expression, a significant association was apparent for the ARHGEF4, PON3, STAT5a, and VAX2 gene transcripts (P<0.05). Herein, we present the first genome-wide DNA methylation analysis in a unique HG-NMIBC cohort, showing extensive and discrete methylation changes relative to normal bladder and low-intermediate-grade tumor PMID: 26929985
- pSTAT5 signaling is implicated in the disease activity of adult and juvenile onset systemic lupus erythematosus PMID: 27041383
- Data show that fyn proto-oncogene protein (FYN) expression is deregulated in acute myeloid leukemia and that higher expression of FYN, in combination with FLT3 protein-ITD mutation, resulted in enrichment of the STAT5 transcription factor signaling. PMID: 26848862
- review describes the role of role of STAT5 in immunity and cancer PMID: 26716518
- We concluded that rs2293157 is an important marker for the therapeutic efficiency of Ara-C-based chemotherapy in patients with AML, especially in the Chinese population. PMID: 26384082
- Decreased expression of STAT5 was associated with metastases in Colon Carcinoma. PMID: 25773877
- PTP1B directly regulates STAT5 phosphorylation and its activation via the cAMP/PKA pathway downstream of the 5-HT7 receptor is involved in the suppression of beta-casein expression in MCF-12A cells PMID: 27016479
- Foxp3 has a rapid turn over in Treg partly controlled at the transcriptional level by the JAK/STAT pathway PMID: 27077371
- prolactin activation of Stat5 results in the formation of a complex between phospho-Stat5 and BRCA1. Formation of this complex does not interfere with nuclear translocation or binding of BRCA1 to the p21 promoter PMID: 26970274
- The innate immune regulator STAT-5 is shown to regulate transcription of the ATR binding factor TopBP1, and this is critical for the induction of the ATR pathway in human papillomavirus-infected keratinocytes. PMID: 26695634
- The two STAT5 isoforms, STAT5a and STAT5b. PMID: 26717567
- that STAT-5, RUNX-2, and FGFR-2 may have a role in the progression of the mucinous phenotype, in which nuclear STAT-5 may inhibit RUNX-2 prometastatic effect PMID: 26551078
- Our study suggests that pyrvinium is a useful addition to T-cell lymphoma treatment, and emphasizes the potential therapeutic value of the differences in the mitochondrial characteristics between malignant and normal T-cells in blood cancer. PMID: 26707639
- support the concept that Jak2-Stat5a/b signaling promotes metastatic progression of prostate cancer by inducing epithelial-to-mesenchymal transition and stem cell properties in prostate cancer cells PMID: 26362718
- D5 Stat5a plays pathogenic role in breast cancer through, at least partly, increasing trimethylation of the IGFBP-7 promoter region, thereby inhibiting IGFBP-7 expression. PMID: 26387651
- CD82 regulated BCL2L12 expression via STAT5A and AKT signaling and stimulated proliferation and engrafting of leukemia cells. PMID: 26260387
- the ETV6/ARG oncoprotein contributes to autonomous cell growth by compensating for the requirement of growth factor through activating STAT5 signaling, which leads to the up-regulation of c-Myc. PMID: 25373509
- Both Stat5a/b genetic knockdown and antiandrogen treatment induced proteasomal degradation of AR in prostate cancer cells. PMID: 25552366
- Upregulation of STAT5A is associated with chronic myeloid leukemia. PMID: 25953263
- High phosphorylated signal transducer and activator of transcription 5 is associated with mammary analogue secretory carcinoma of the salivary gland. PMID: 26252941
- These data provide the first definitive evidence for a contribution of STAT5a/b to the sex bias in pulmonary hypertension in the hypoxic mouse and implicate reduced STAT5 in the pathogenesis of the human disease. PMID: 25470773
- STAT5A positively regulates levels of DNMT3A, resulting in inactivation of tumor suppressor genes by epigenetic mechanisms in acute myeloid leukemia cells. PMID: 26059451
- constitutively active STAT5A(S710F) escapes from SFK-mediated cytoplasmic retention by enhancing STAT5A dimer stability PMID: 25885255
- The role of STAT proteins, including STAT5, and NF-kappa B in the death of Caco 2 cells incubated with Entamoeba histolytica is reported. PMID: 25352693
顯示更多
收起更多
-
亞細(xì)胞定位:Cytoplasm. Nucleus. Note=Translocated into the nucleus in response to phosphorylation.
-
蛋白家族:Transcription factor STAT family
-
數(shù)據(jù)庫鏈接:
Most popular with customers
-
-
YWHAB Recombinant Monoclonal Antibody
Applications: ELISA, WB, IHC, IF, FC
Species Reactivity: Human, Mouse, Rat
-
Phospho-YAP1 (S127) Recombinant Monoclonal Antibody
Applications: ELISA, WB, IHC
Species Reactivity: Human
-
-
-
-
-